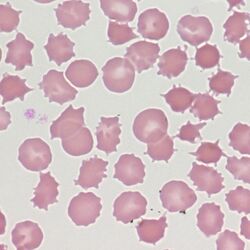

Acanthocytes
From haematologyetc.co.uk
(spur cells or sputnik cells)
Derivation: Greek acantha [thorn]
Appearance
The cell body is generally dense and contracted, but the major feature is the presence of around 2-20 spicules. These are irregularly distributed across surface of the cell and may be sharp or club shaped.
Appearance: The cell body may be dense or may retain central pallor, the characteristic projections are few in number and are irregularly distributed across the cell surface. Projections are long and may end in points or in small club-like projections.The abnormal cells may be frequent or rare depending on the cause, and may be the sole abnormal form present. In other cases other abnormal cell types such as target cells or features of splenectomy may be found. The cells often appear a little smaller and more dense than normal erythrocytes.
Significance
These cells arise from an identifiable cause and care should be taken to identify this cause. Infrequent acanthocytes are often encountered in hyposplenic conditions, but where they are very frequent this may indicate an uncommon or serious cause which needs to be communicated to clinicians.
Pitfalls
Acanthocytes should be distinguished from echinocytes (which have more frequent, short, blunt and regularly distributed projections). This distinction may be difficult for very early or late forms of the acanthocyte, but differences between established forms are generally distinctive (see clinical images).
1. Causes of acanthocytes
| Primary Causes |Altered cell membrane lipid balance (frequent abnormal forms) |
|---|
| Abetalipoproteinaemia or hypobetalipoproteinaemia |
| Severe liver disease |
| Zieve Syndrome |
| Anorexia nervosa or malnutrition |
| Hypothyroidism and myxoedema |
| Neuroacanthocytosis |
| Age-related changes to cell membrane (generally infrequent abnormal forms) |
| Infrequent forms occurs as blood cells age – more frequent in hyposplenism |
| Abnormal cell membrane proteins |
| McLeod phenotype |
| Null Lutherian |
| Metabolic (abnormal forms may be visible only after splenectomy) |
| Pyruvate kinase deficiency (acanthocytes are atypical and partly resemble echinocytes) |
2. Clinical Examples:acanthocytes
Clinical Image 1 A very well formed acanthocyte with 8 blunt ended long projections and a dense cell body. There are a range of other abnormal red cell forms and a high platelet count (reflecting a hyposplenic state). Clinical disorder: post-splenectomy appearances
Clinical Image 2 Very frequent acanthocytes with typical features. This image demonstrates the range of different stages of formation from early spicule formation affecting otherwise normal red cells, through to typical forms with well-formed spicules, and finally late stages with dense spherical bodies and very fine spicules. Clinical disorder: abetalipoproteinaemia.
Clinical Image 3 Acanthocytes formed in severe systemic disease. Shown at slightly higher power there are again numerous acanthocytes, the distortion in this case reflects more widespread damage to red cells as part of the generalised illness of this patient. Clinical disorder: severe liver disease causing coagulopathy and spur cell (acanthocytic) anaemia.
Clinical Image 4 A typical image of the acanthocytes formed after spleen removal in a case of pyruvate kinase deficiency. Prior to splenectomy the abnormal cells may be very infrequent. The appearance of the acanthocytes in this condition is distinctive – the projections are generally broad based and short, sharing features with echinocytes. Clinical disorder: pyruvate kinase deficiency post-splenectomy.
Pathobiology of acanthocytes
The characteristic projections arise from an imbalance in the lipid content of the cell membrane. This imbalance causes a preferential expansion of the outer membrane layer resulting in projections. Acanthocytes therefore arise most commonly in conditions that alter plasma lipid composition such as liver disease, although occasionally may arise from altered membrane protein composition such as the McLeod syndrome.